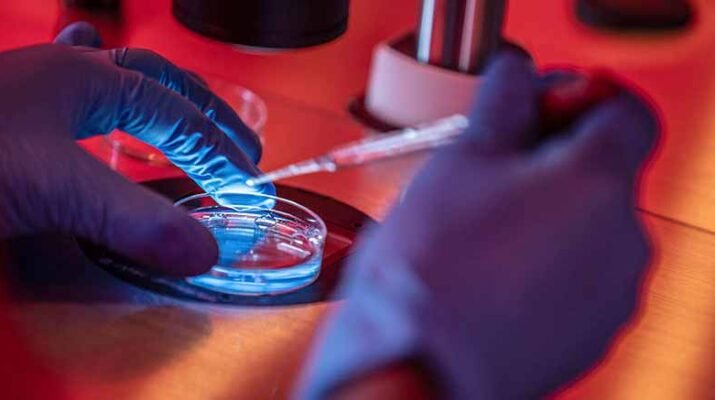
fertilización in vitro

Nada que detenga la fraudulenta elección judicial Tras La Verdad, por Héctor Parra Rodríguez Viernes 18 de abril de 2025 El oficialismo ha cometido
Etiqueta: EUA
Trump impone aranceles a islas sin humanos, habitan focas y pingüinos
Trump impone aranceles a un archipiélago sin humanos pero sí con focas y pingüinos Trump anunció un arancel del 10% el 2 de
Agradecimientos mutuos entre Sheinbaum y Trump
Agradecimientos mutuos entre Sheinbaum y Trump Tras La Verdad, por Héctor Parra Rodríguez Jueves 6 de marzo de 2025 Se lee de los comunicados
Lenta, insegura y timorata Claudia Sheinbaum
Lenta, insegura y timorata Claudia Sheinbaum Tras La Verdad, por Héctor Parra Rodríguez Martes 4 de marzo de 2025 Siempre sí cumplió la
Mentirosa, manipuladora e ignorante la presidente de México
Mentirosa, manipuladora e ignorante la presidente de México Tras La Verdad, por Héctor Parra Rodríguez Domingo 2 de marzo de 2025 La presidente Claudia
A punto de quebrarse por la fuerte doblada
A punto de quebrarse por la fuerte doblada Tras La Verdad, por Héctor Parra Rodríguez Viernes 28 de febrero de 2025 AMLO pervirtió
EUA planea hacer centros de detención para indocumentados
EUA planea hacer centros de detención de migrantes en diez bases militares La idea es que estos centros sean el primer paso para
Mucha preocupación por un delincuente
Mucha preocupación por un delincuente Tras La Verdad, por Héctor Parra Rodríguez Sábado 22 de febrero de 2025 Antes con AMLO, ahora con Claudia
Sudáfrica inauguró el G20 con la ausencia de EUA
Sudáfrica reúne al G20… pero no va EUA Sudáfrica inauguró la reunión de los ministros de Relaciones Exteriores del G20 en Johannesburgo con
Amplían acceso a la fertilización in vitro en EUA
Donald Trump firma orden para ampliar acceso a la fertilización in vitro Donald Trump amplía acceso a la fertilización in vitro El presidente